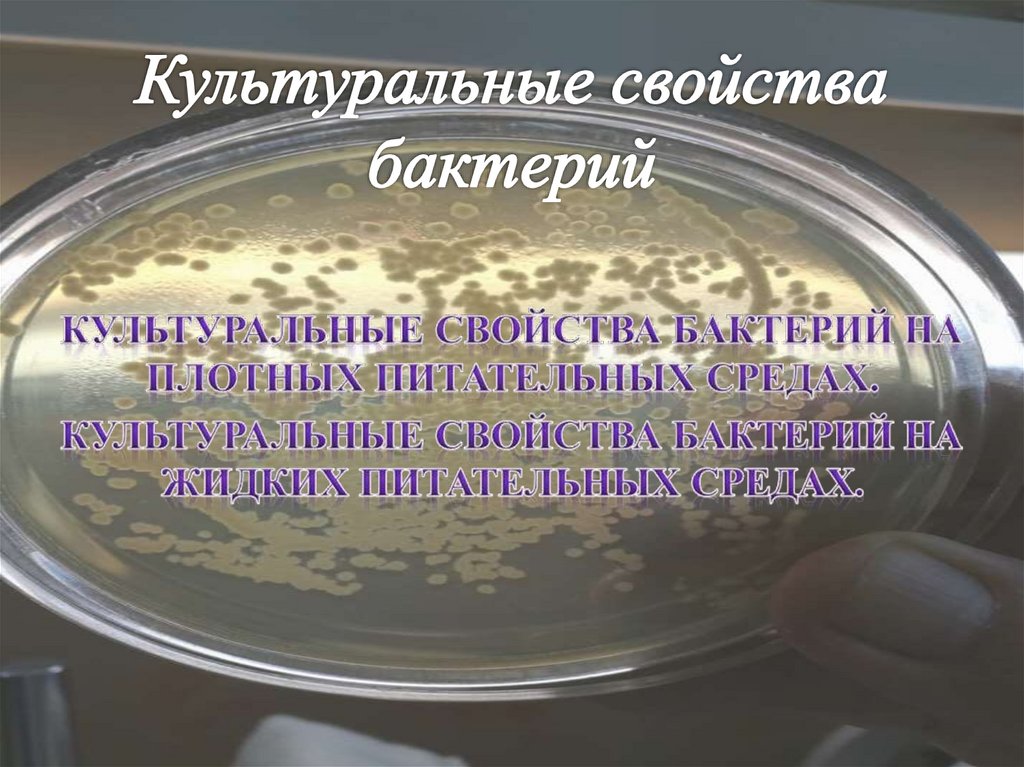
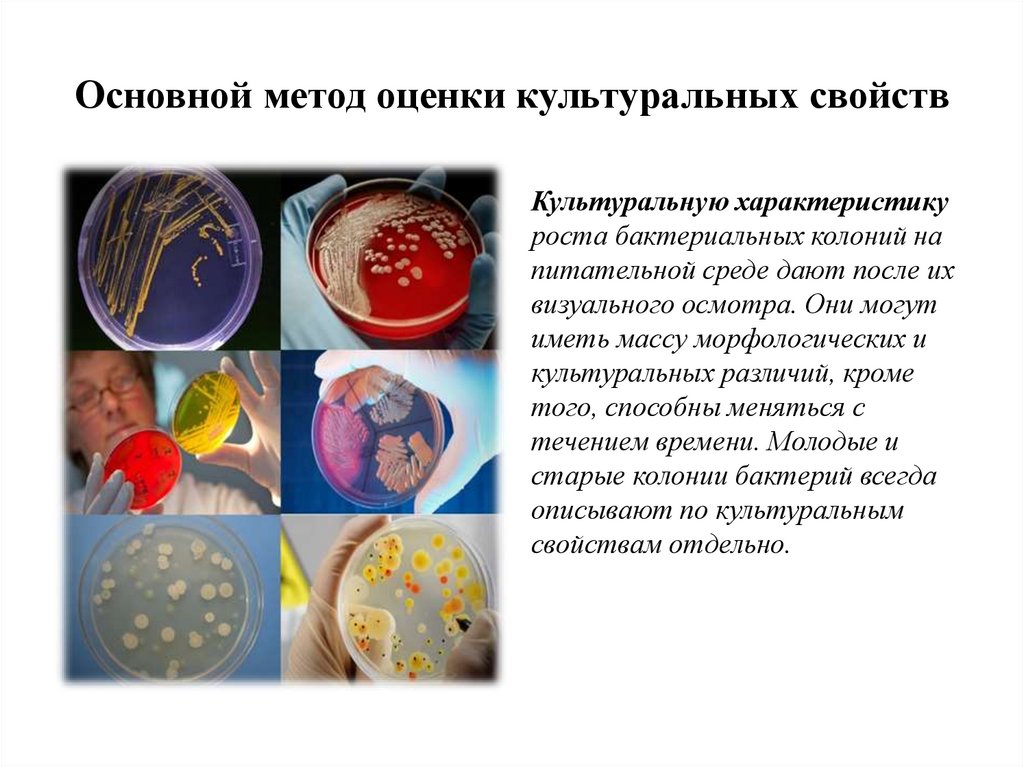
Основной метод оценки культуральных свойств
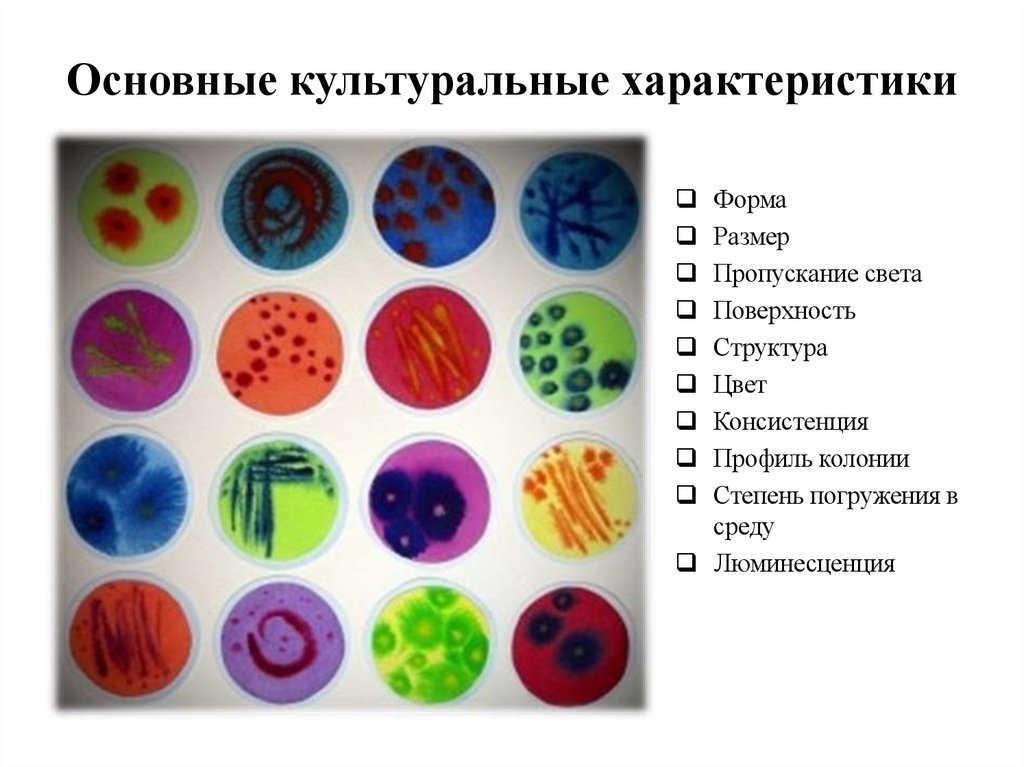
Основные культуральные характеристики
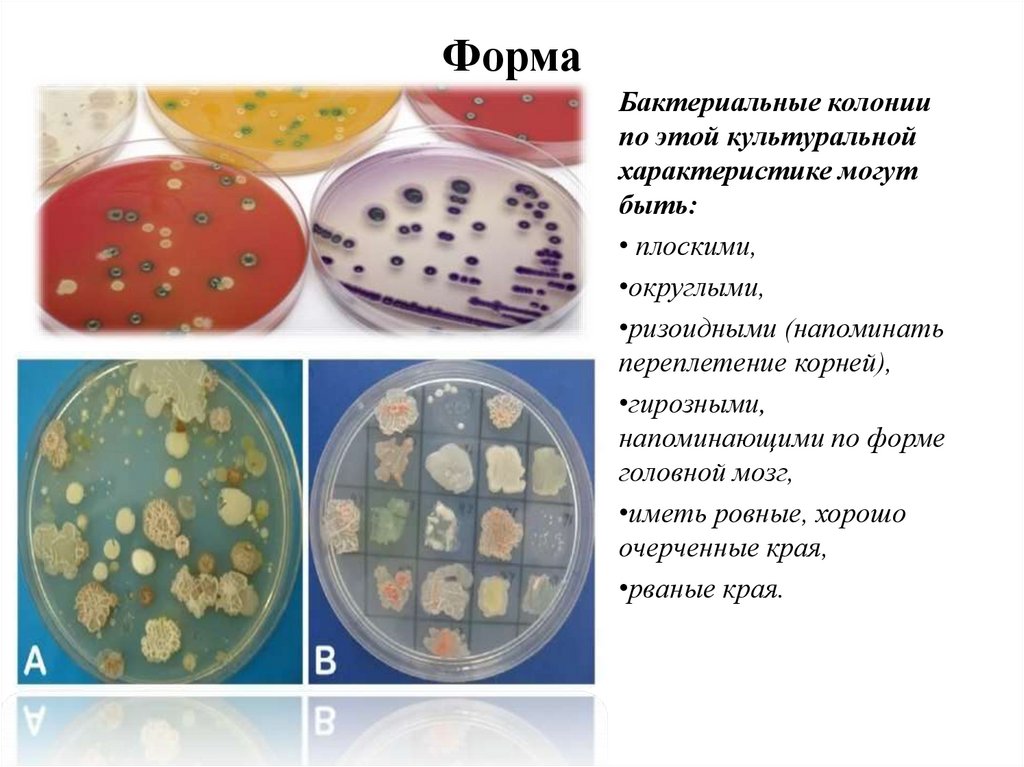
Форма
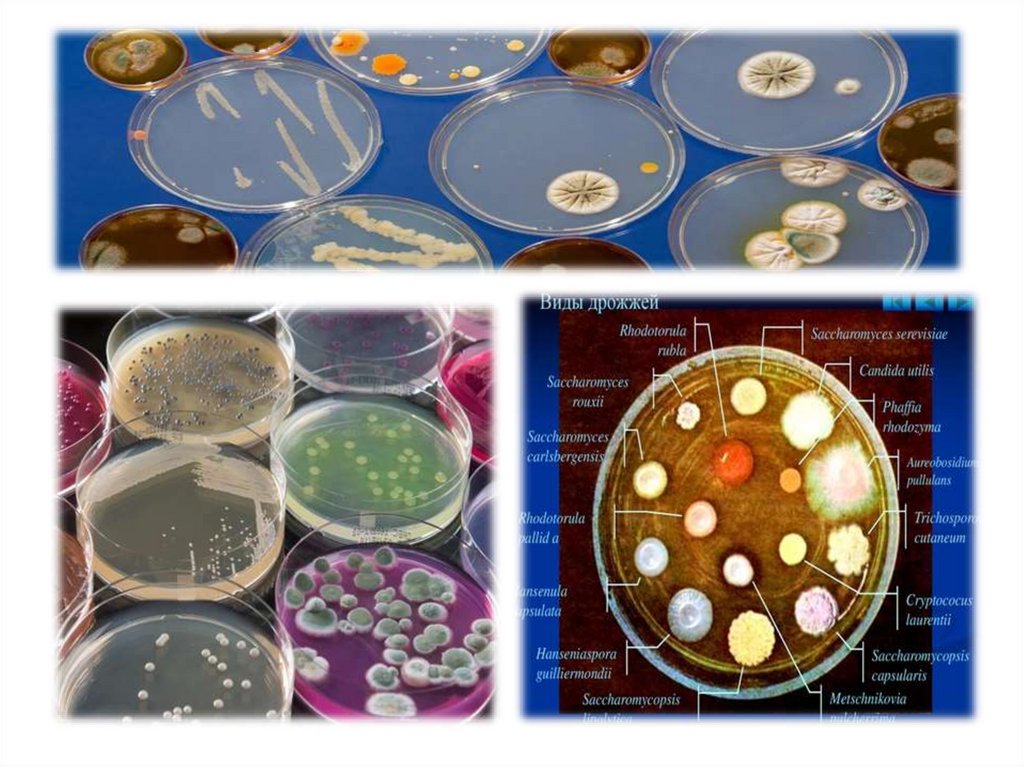
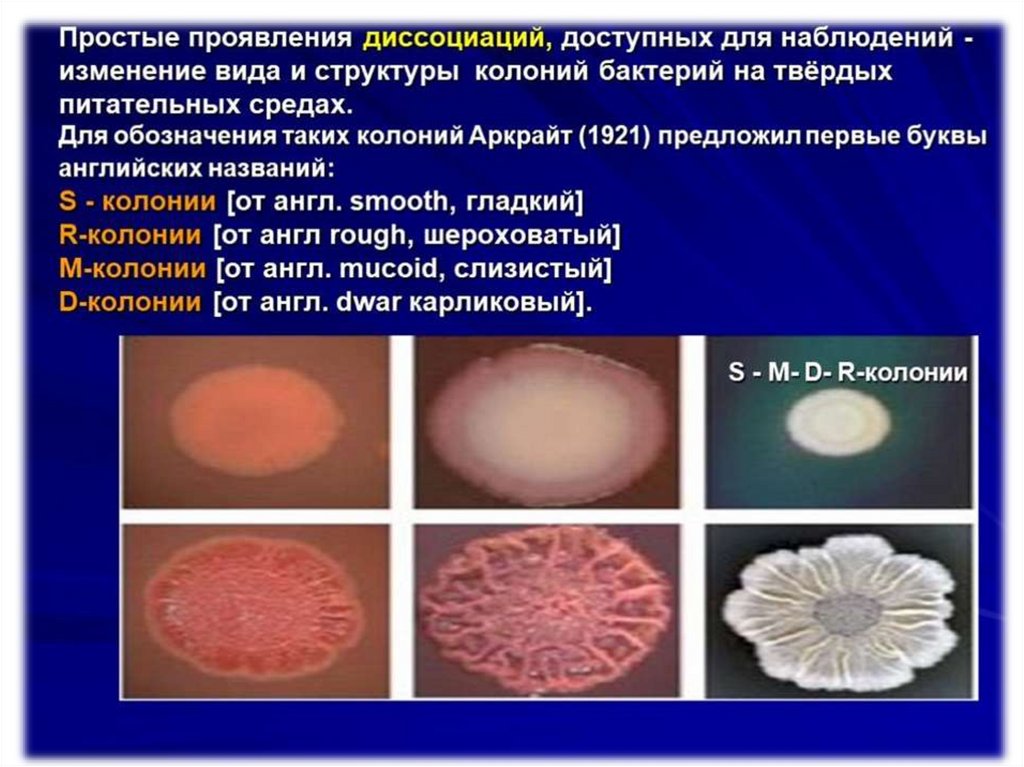
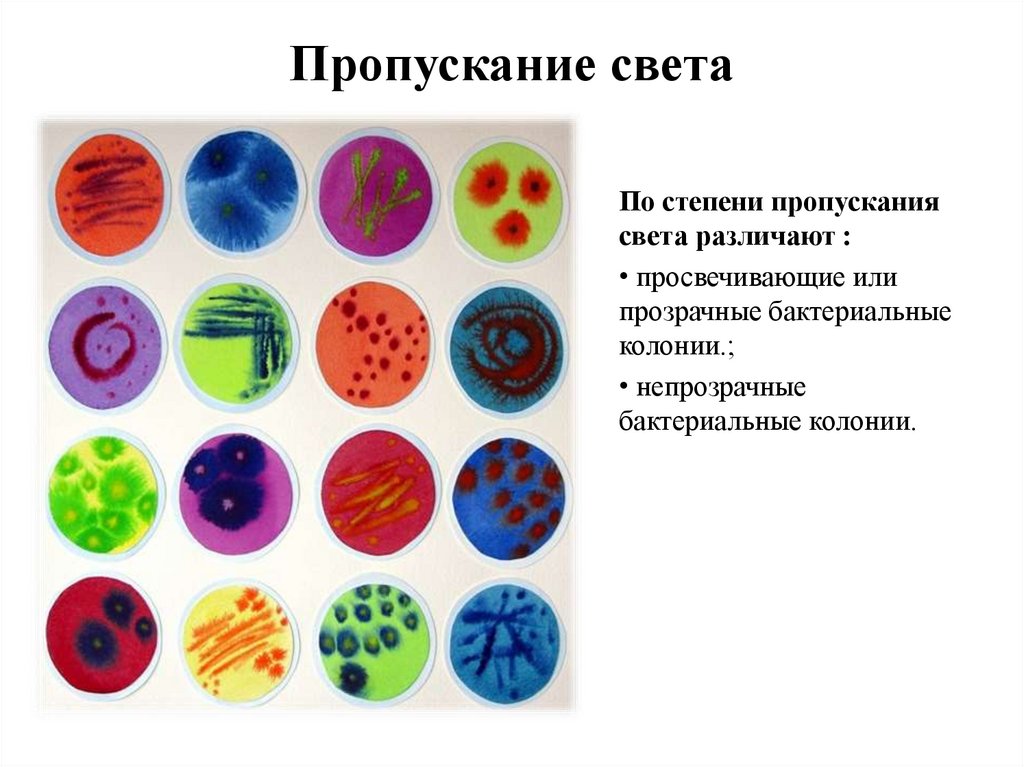
Пропускание света
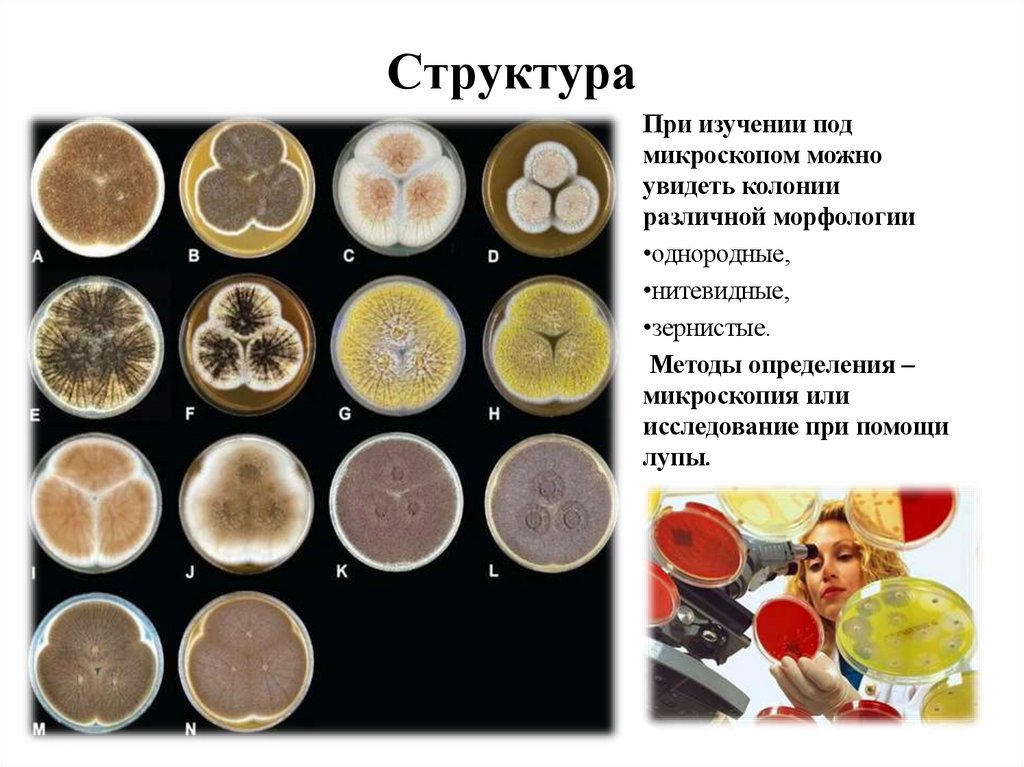
Структура
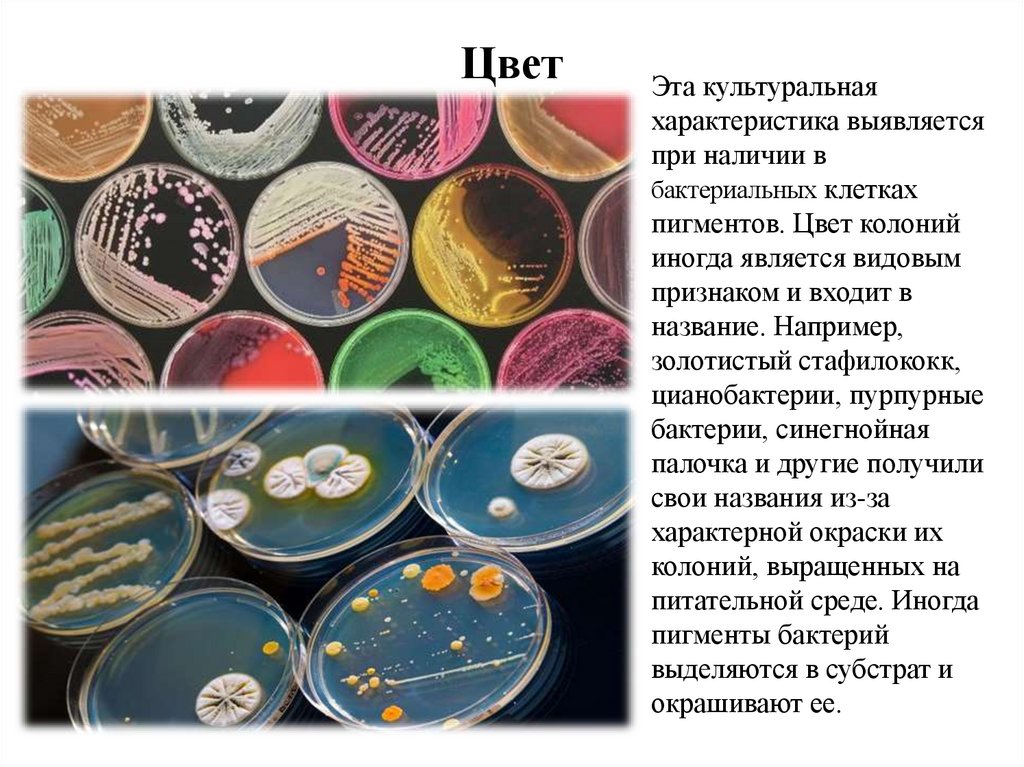
Цвет
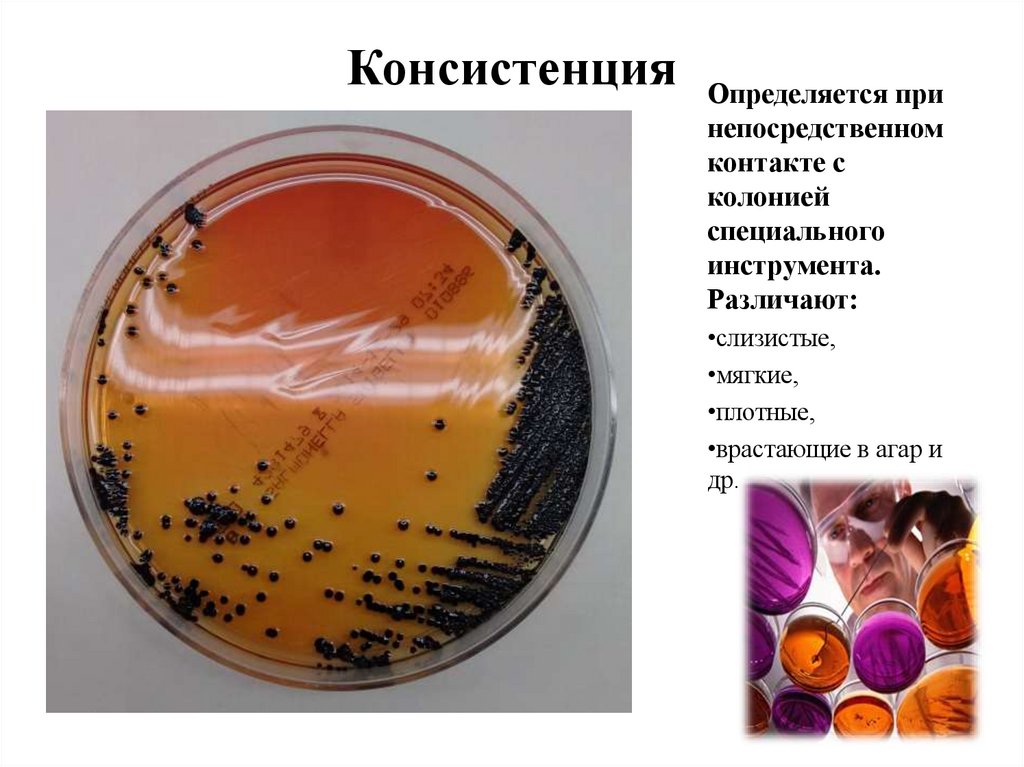
Консистенция
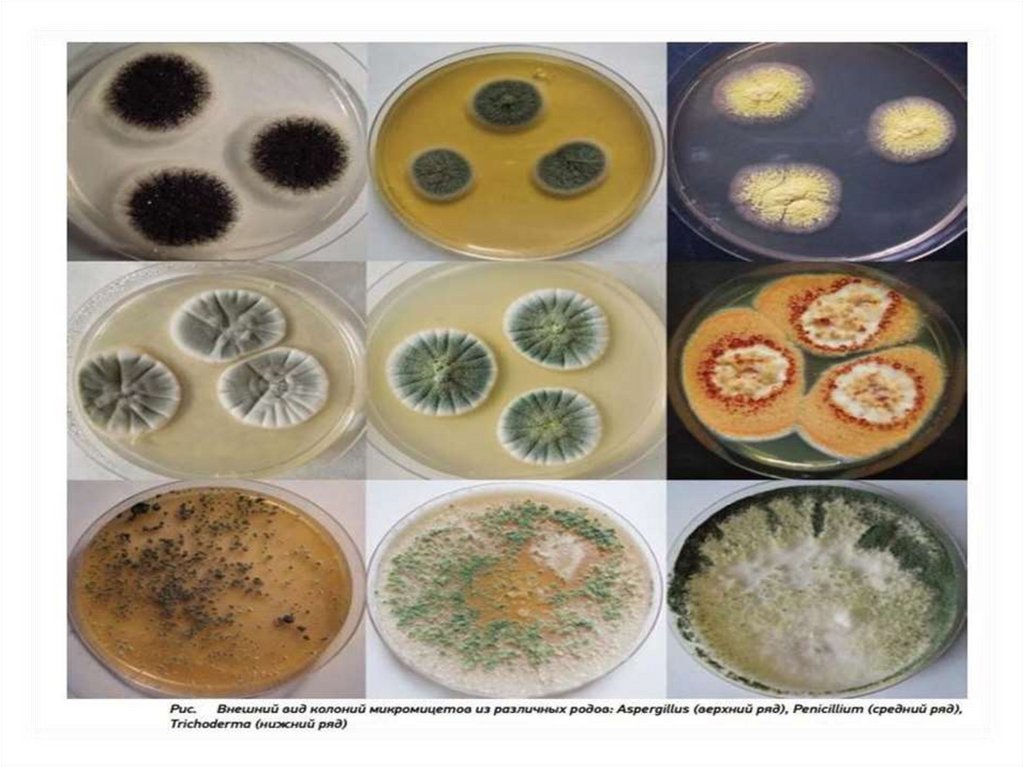
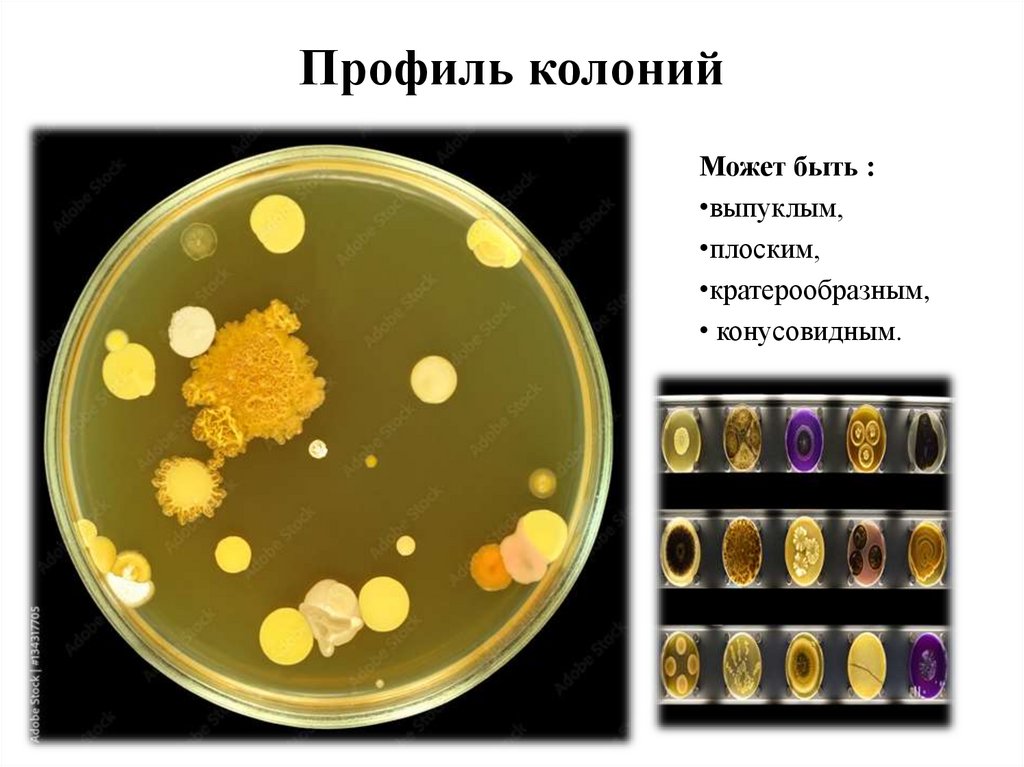
Профиль колоний
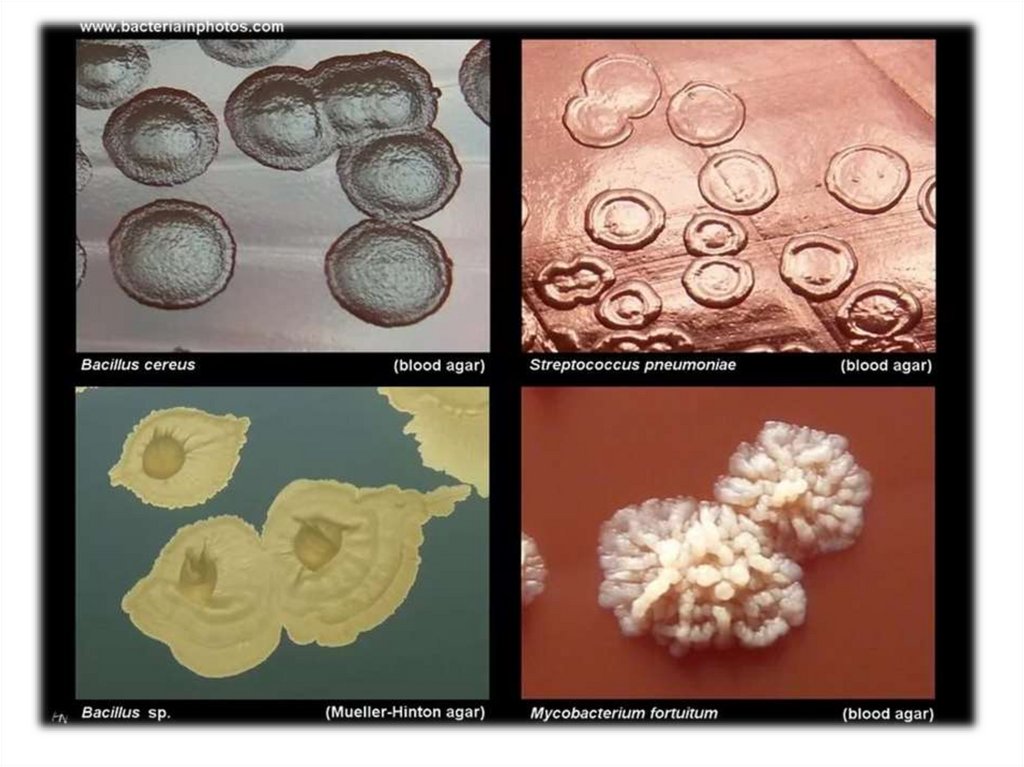
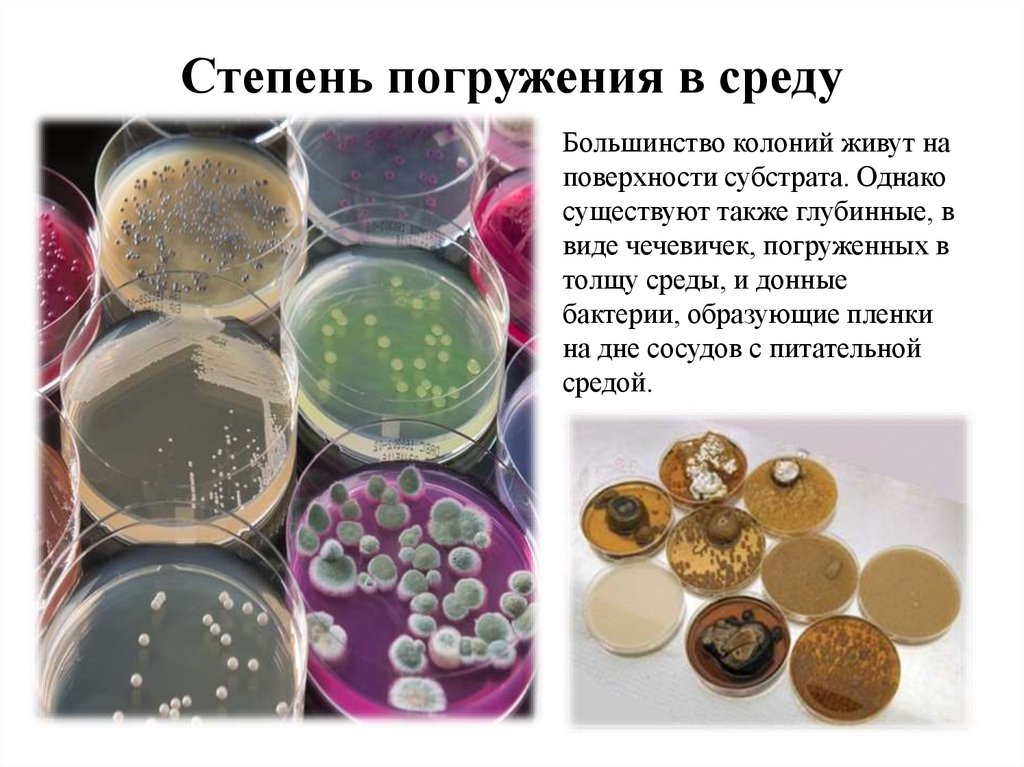
Степень погружения в среду
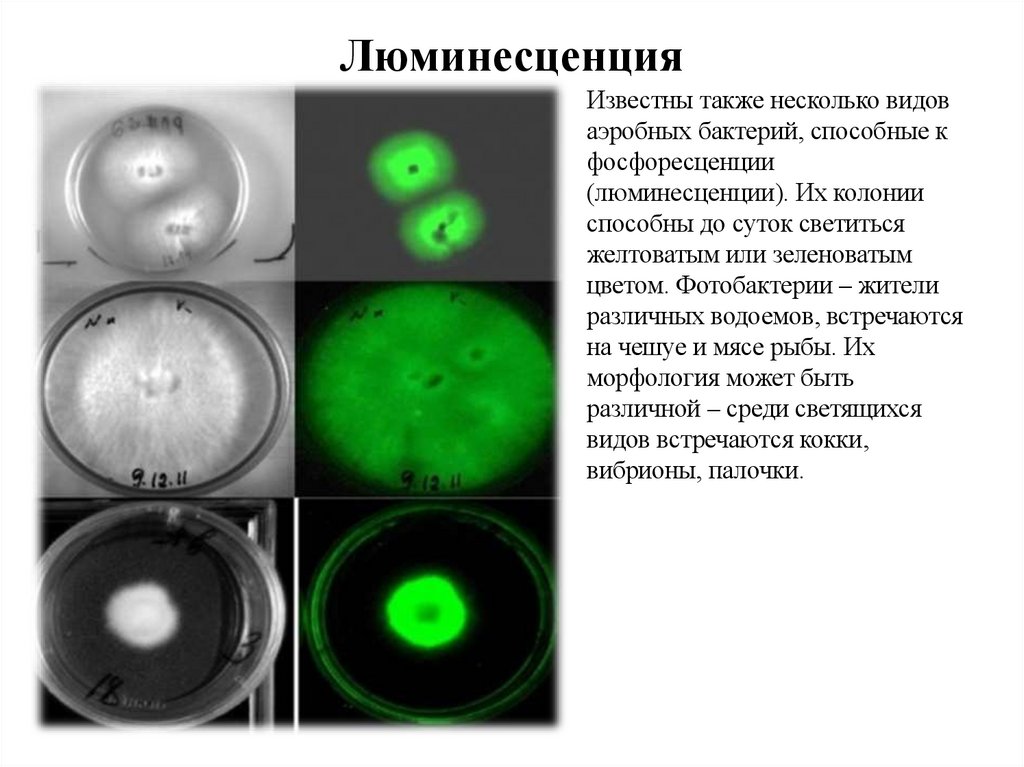
Люминесценция
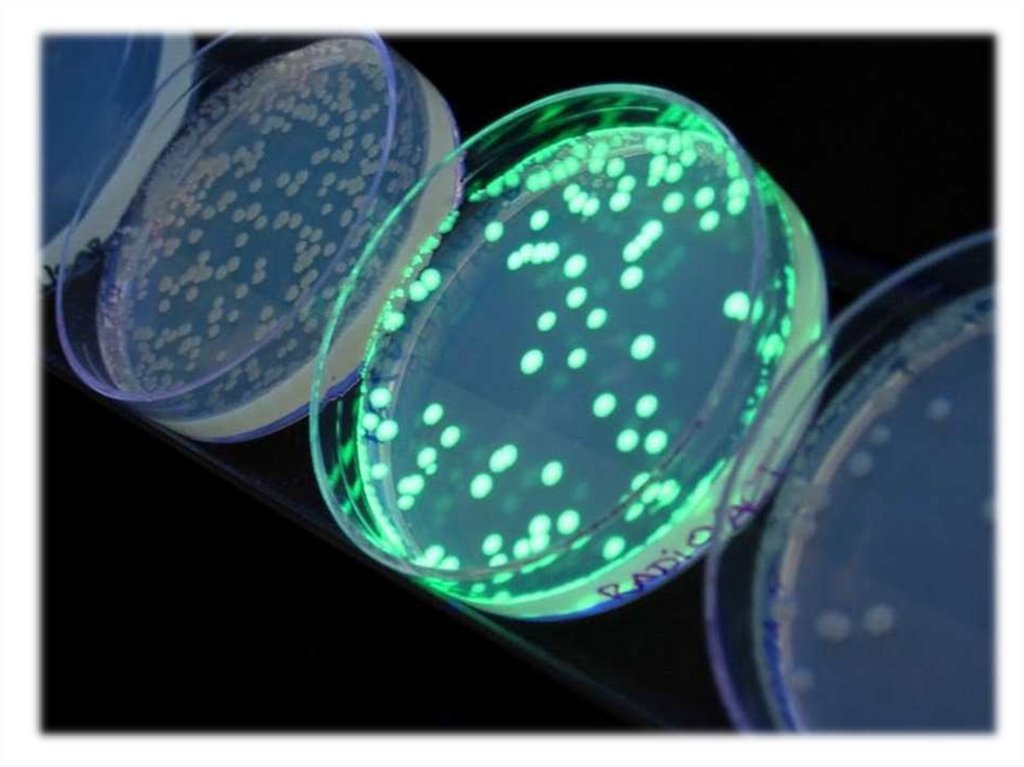
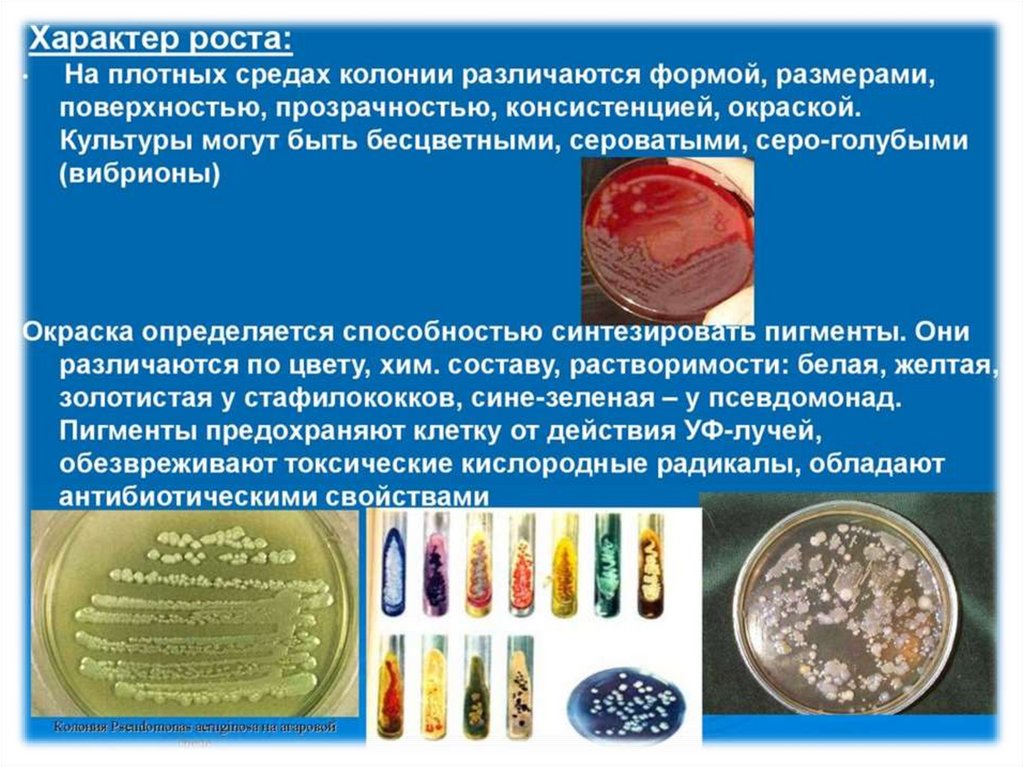
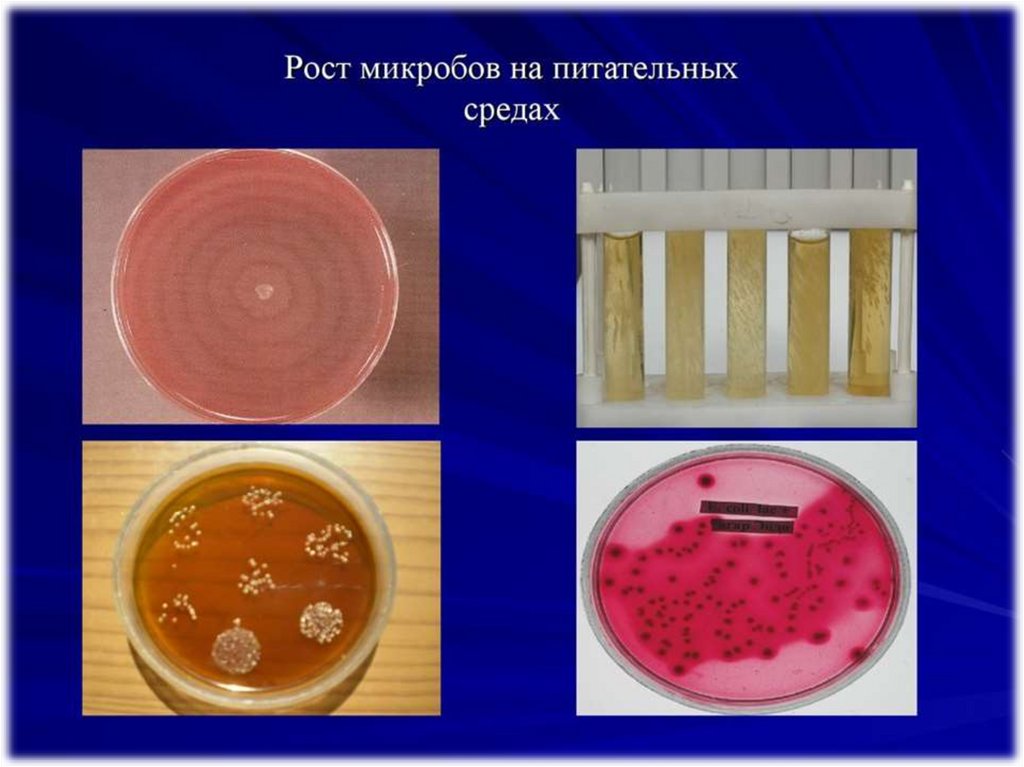
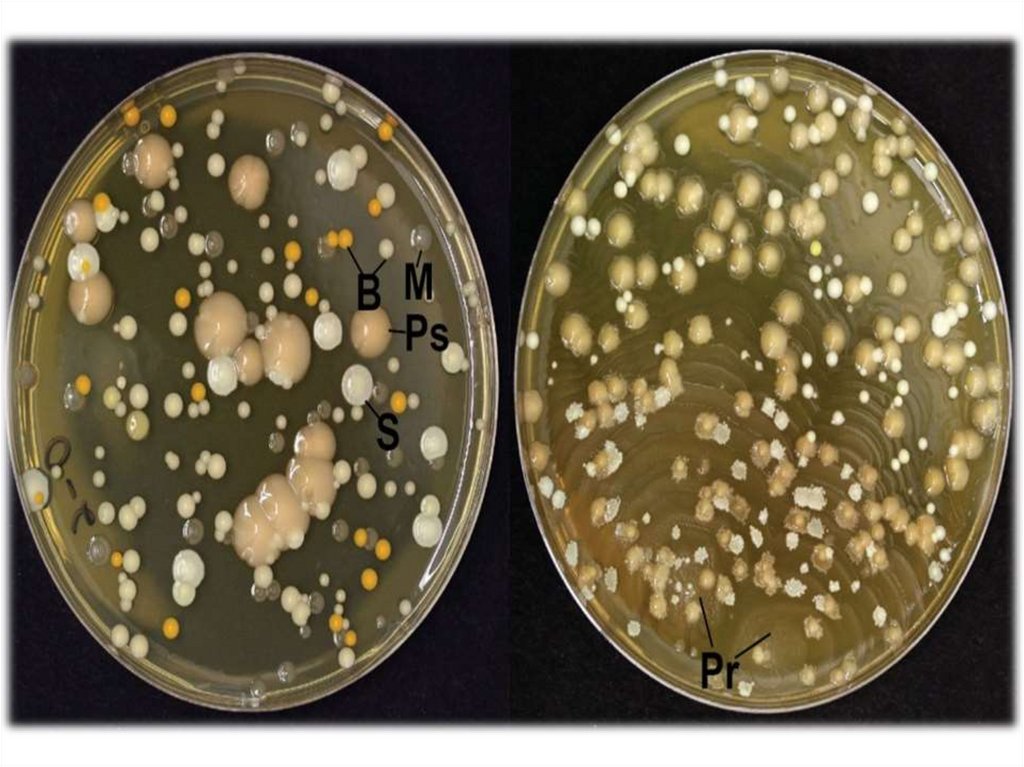
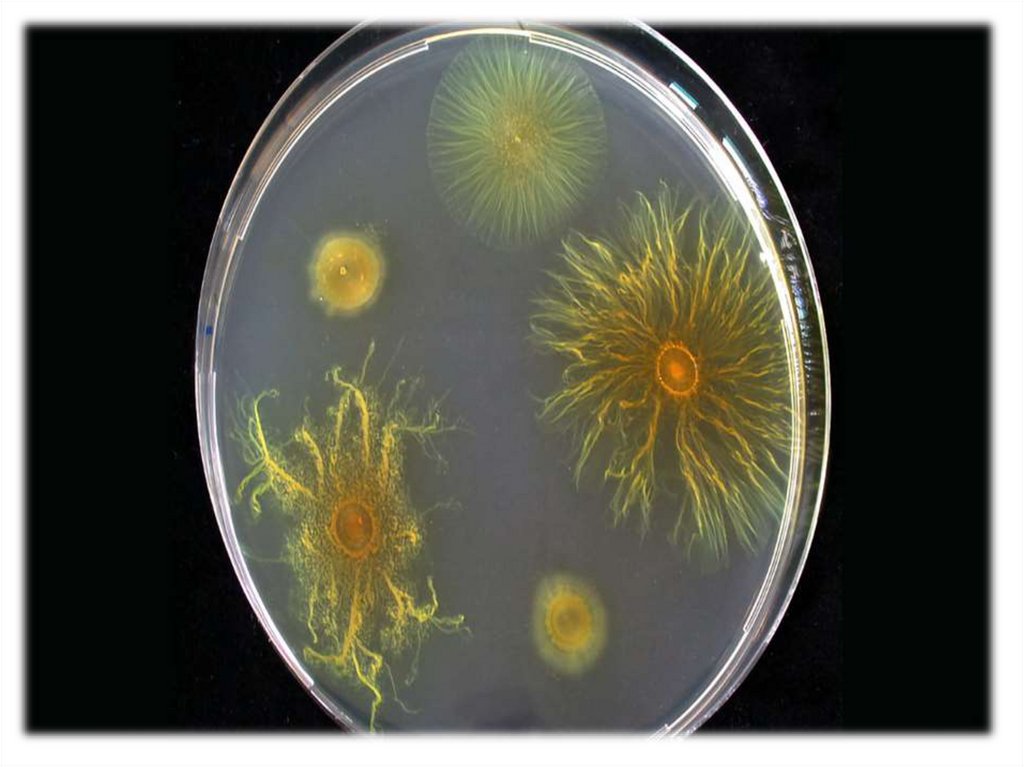
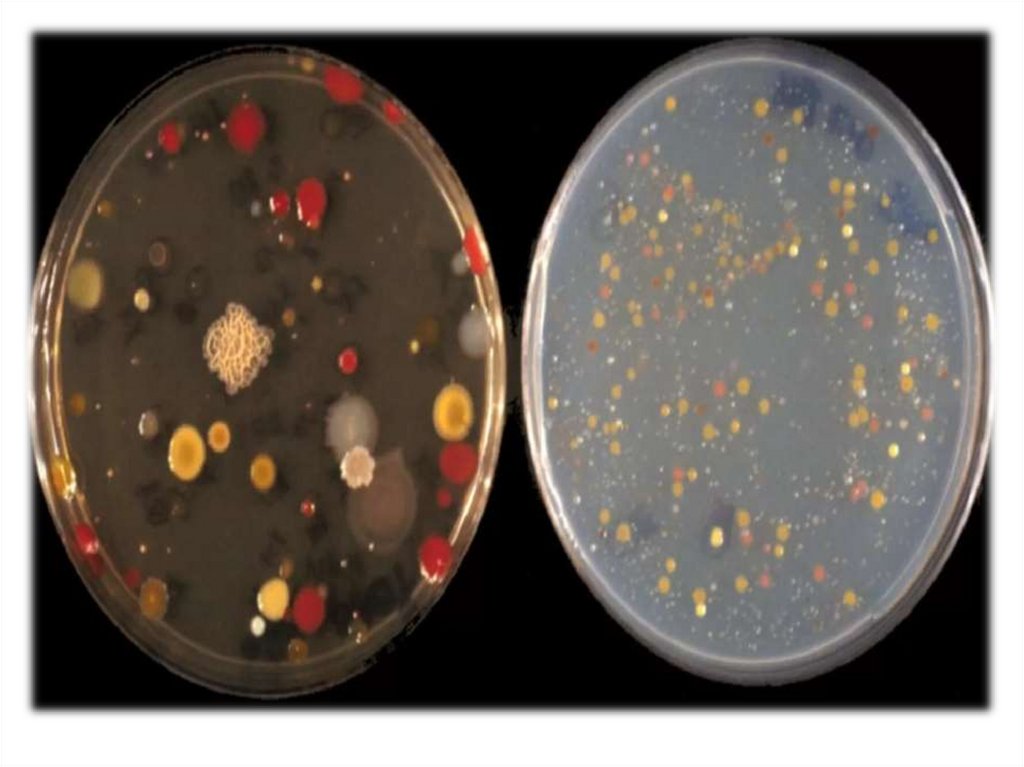
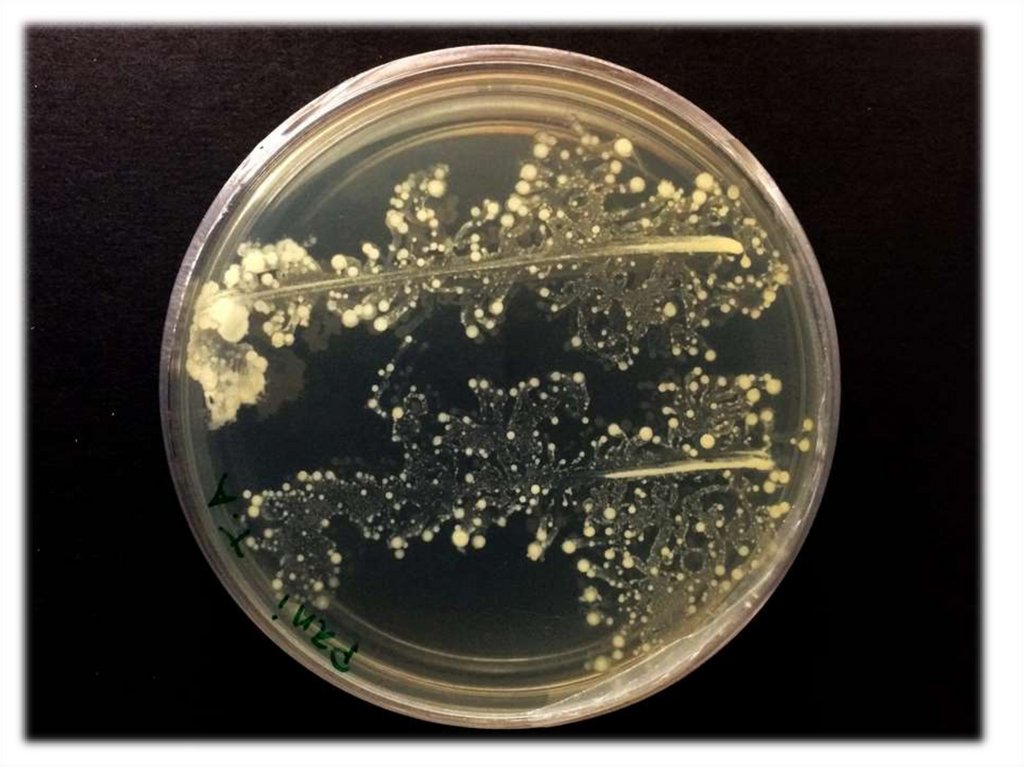

Similar presentations:
Культуральные_свойства_бактерий_на_плотных_и_жидких_питательных
1. Культуральные свойства бактерий
2. Что такое культуральные свойства?
К культуральным свойствамотносятся внешний вид и форма
колоний (это называется
морфологией колоний), способ
роста на плотной и жидкой
питательной среде, требования к
ее составу, характеризующие
потребность бактериальных
колоний в субстратах и
витаминах, аэробных или
анаэробных условиях.
3. Основной метод оценки культуральных свойств
Культуральную характеристикуроста бактериальных колоний на
питательной среде дают после их
визуального осмотра. Они могут
иметь массу морфологических и
культуральных различий, кроме
того, способны меняться с
течением времени. Молодые и
старые колонии бактерий всегда
описывают по культуральным
свойствам отдельно.
4. Основные культуральные характеристики
ФормаРазмер
Пропускание света
Поверхность
Структура
Цвет
Консистенция
Профиль колонии
Степень погружения в
среду
Люминесценция
5. Форма
Бактериальные колониипо этой культуральной
характеристике могут
быть:
• плоскими,
•округлыми,
•ризоидными (напоминать
переплетение корней),
•гирозными,
напоминающими по форме
головной мозг,
•иметь ровные, хорошо
очерченные края,
•рваные края.
6. Размер
Важнаяхарактеристика
морфологии колоний.
Различают :
•мелкие колонии
диаметром 1-3 мм,
•средние размером от 2
до 4 мм,
• крупные - 4 мм и более.
7.
8.
9. Пропускание света
По степени пропусканиясвета различают :
• просвечивающие или
прозрачные бактериальные
колонии.;
• непрозрачные
бактериальные колонии.
10. Поверхность
Поверхность можетбыть:
• шероховатой,
•гладкой,
•морщинистой,
•блестящей,
•влажной,
•тусклой,
•слизистой,
•сухой.
11. Структура
При изучении подмикроскопом можно
увидеть колонии
различной морфологии
•однородные,
•нитевидные,
•зернистые.
Методы определения –
микроскопия или
исследование при помощи
лупы.
12. Цвет
Эта культуральнаяхарактеристика выявляется
при наличии в
бактериальных клетках
пигментов. Цвет колоний
иногда является видовым
признаком и входит в
название. Например,
золотистый стафилококк,
цианобактерии, пурпурные
бактерии, синегнойная
палочка и другие получили
свои названия из-за
характерной окраски их
колоний, выращенных на
питательной среде. Иногда
пигменты бактерий
выделяются в субстрат и
окрашивают ее.
13. Консистенция
Определяется принепосредственном
контакте с
колонией
специального
инструмента.
Различают:
•слизистые,
•мягкие,
•плотные,
•врастающие в агар и
др.
14.
15. Профиль колоний
Может быть :•выпуклым,
•плоским,
•кратерообразным,
• конусовидным.
16.
17. Степень погружения в среду
Большинство колоний живут наповерхности субстрата. Однако
существуют также глубинные, в
виде чечевичек, погруженных в
толщу среды, и донные
бактерии, образующие пленки
на дне сосудов с питательной
средой.
18. Люминесценция
Известны также несколько видоваэробных бактерий, способные к
фосфоресценции
(люминесценции). Их колонии
способны до суток светиться
желтоватым или зеленоватым
цветом. Фотобактерии – жители
различных водоемов, встречаются
на чешуе и мясе рыбы. Их
морфология может быть
различной – среди светящихся
видов встречаются кокки,
вибрионы, палочки.
19.
20. Характеристики по виду среды
В жидком субстрате морфология
бактериальных колоний
характеризуется образованием
равномерной мути, пленки или
осадка.
В полужидких при посеве уколами
подвижные бактерии вызывают
помутнение в толще среды вокруг
места посева, а неподвижные –
только в самом месте укола.
Некоторые бактерии в аэробных и
анаэробных условиях выделяют
различные газы (индол, скатол,
меркаптан, сероводород, масляная
кислота, диэтиловый эфир и тому
подобное).

biology
biology








